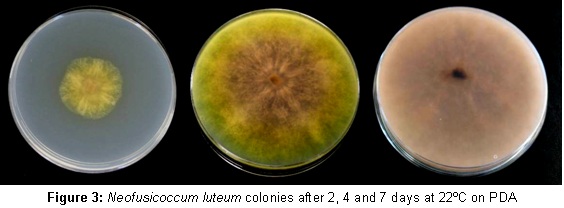
Neofusicoccum luteum colonies  Neofusicoccum luteum colonies
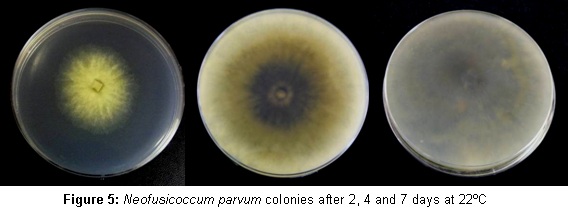
Neofusicoccum parvum colonies  Neofusicoccum parvum colonies

Pintos, C., Redondo, V., Chaves, M., Rial, C., Aguín, O., Mansilla, J.P. and Salinero, C.
Estación Fitopatolóxica Do Areeiro, Deputación de Pontevedra, Subida a la Robleda s/n. E-36153 Pontevedra, Spain
Camellia species, and their hybrids and cultivars, are ornamental plants widely disseminated in the Galicia region (NW Spain). They are being propagated in several ornamental nurseries, and can also be found in public parks and historical gardens in our region. However, at present there are several diseases that are damaging these plants. Several fungi have been reported to cause Camellia root rot including Armillaria mellea, Phytophthora cinnamomi and Rosellinia necatrix. Camellia spp. are also affected by a number of aerial fungal diseases namely Botrytis cinerea, Ciborinia camelliae, Colletotrichum gloeosporoides, Meliola camelliae, Pestalotia guepinii, Phomopsis camelliae-japonicae and Phytophthora ramorum (Mansilla et al. 2002, Pintos et al. 2003). Of these, Ciborinia camelliae and Phytophthora ramorum are included in the European Plant Protection Organization (EPPO) Pest lists (EPPO A2 list and EPPO Alert list, respectively) and they were detected, for the first time in Spain, in the Galician region. There are several references of trunk diseases found in Camellia spp. of which Camellia dieback and canker caused by Glomerella cingulata is the most cited as wood disease in scientific literature worldwide (Baxter et al. 1982; Dickens and Cook, 1989). Some Botryosphaeriaceae species have also been reported for Camellia spp. Plants affected show canker dieback and leaf spots (Duke, 1983; Buckley and Gould, 2000; Cunnington et al. 2007), but so far Neofusicoccum species (Botryosphaeriaceae family) have not been identified yet on Camellia in Spain.
In March 2011 decayed C. japonica plants were submitted to the laboratory of the Estación Fitopatolóxica do Areeiro. Affected plants showed leaf spots, cankered branches and dieback. Samples of leaves and wood were processed and two Neofusicoccum species were isolated.

Figure 1: Symptoms in Camellia spp.
Wood and leaf samples were surface sterilized in 0.5 % sodium hypochlorite for 3 min and rinsed in sterile distilled water. Small pieces of tissue were cut from the margin of necrotic tissue and placed onto malt agar (MA) amended with streptomycin (25 μg ml-1). Samples were incubated at 23°C in darkness. Fungi growing were isolated, transferred onto Potato dextrose agar (PDA) and incubated at 25°C in darkness. Cultures displaying morphological characteristics associated with Neofusicoccum species were subcultured onto 1% water agar (AA) containing autoclaved Pinus spp. needles and then incubated at 25°C under intermittent light (12 h) for 1-2 weeks to encourage pycnidium production (Crous et al. 2006). Single conidia cultures were prepared taking a conidiomata and crushing it in a drop of sterile water. A portion of water was spread over a PDA plate and germinating single conidia were transferred to a new PDA plate after 24 hours. The isolates were incubated on PDA for 24 hours at different temperatures and radial growth was measured on four pre-marked radii at right angles. Neofusicoccum spp.were identified by cultural, physiological and morphological characteristics and confirmed by molecular analysis. Fungal DNA was directly extracted from mycelia grown on plates, using a commercial kit. PCR reactions were carried out with primers ITS1 and ITS4 (White et al., 1990) to amplify the ITS region. Products from PCR reactions were electrophoresed on a 2% agarose gel, then stained with GelRed, and visualized with a UV transilluminator. The size of PCR products was estimated by comparison with a 100 bp standard ladder (Marker XIV, Roche Diagnostics). Amplified products were sequenced with the same primers used for PCR reactions and analyzed in an ABI Prism 3130 Genetic Analyzer sequencer (Applied Biosystems). Sequences obtained were analyzed with the BLAST alignment program of the NCBI and submitted to GenBank database.
One monosporic isolate for each Neofusicoccum species was selected. Artificial inoculations were conducted in April 2011 in thirty 4 year-old Camelia japonica seedlings grown in pots. One shallow cut was made in the stem of each plant. A colonized agar plug, from the margin of a growing colony of N. luteum, was inserted in every wound and was sealed with parafilm®. Another ten 4 year-old plants were inoculated with N. parvum following a similar procedure whereas the control seedlings received only sterile PDA agar plugs. Plants were labelled and maintained in a chamber under controlled temperature (25 ± 2°C) and humidity (70-80%). 6 months after inoculations, the length of external lesions was recorded. Surface sterilized wood pieces taken from necrotic tissues were plated on PDA to reisolate inoculated fungi so as to fulfil Koch´s postulates.

Single conidia cultures produced two distinct types of colonies on potato dextrose agar (PDA) at 25°C. In type 1 colonies isolates yielded a sparse aerial mycelium and a characteristic yellow pigment which is more intense after 3 days, thereafter becoming pink-violaceous and gradually obscuring to dark grey.
Growth occurred from 4-38°C with an optimum at 28°C. Conidia were hyaline, fusiform, aseptate, thin-walled, averaged 22.2 (16.7 to 27.4) x 6.2 (4.6 to 7.5) μm in size and a length/width (L/W) ratio of 3.6 ± 0.4 (n=100). Isolates were identified as Neofusicoccum luteum (Pennycook et al. 1985, Phillips et al. 2002, Crous et al. 2006).

Type 2 colonies produced a dense mycelia, initially yellow which quickly became grey. Isolates presented a marked diurnal zonation. Growth ranged from 4-38°C with an optimum at 28°C.
Conidia were hyaline, elliptical, aseptate, thin-walled, averaged 18.2 (13.5 to 22.8) x 6.1 (4.8 to 7.1) μm in size and a ratio L/W= 3.0 ± 0.3 (n=100). These isolates were identified as Neofusicoccum parvum (Pennycook et al. 1985, Crous et al. 2006). Neofusicoccum luteum was isolated from leaf samples and wood whereas N. parvum could only be isolated from leaves.

Identity of both species was confirmed by DNA sequence analysis of the ITS regions. Comparison of type 1 and type 2 sequences showed 100% homology with N. luteum and N. parvum (accession numbers EU673311 and EU650672, respectively). The sequences of N. luteum and N. parvum were submitted to GenBank with accession numbers JN812037 and JN812036.
After two months, inoculated plants started to show cankers around the point of inoculation. After 6 months, length of necroses measured an average of 20.8 mm long in N. luteum and 31.7 mm in N. parvum. Both species were reisolated from stems of inoculated plants but not from the controls.

Figure 7: Symptoms of camellia associated with N. parvum: (a) cross-section (b) stem canker (c) internal necroses. Symptoms of camellia canker associated with N. luteum: (d) stem canker (e) internal necroses (f) cross-section.
Neofusicoccum is a genus that comprises many species, it has a cosmopolitan distribution and can cause dieback and canker diseases of woody hosts (Denman et al. 2000). Neofusicoccum parvum and Neofusicoccum luteum are polyphagous fungi detected in multiple hosts such as grapevine, avocado, mango or rhododendron.
To our knowledge, this is the first report of N. luteum and N. parvum on C. japonica in Spain.
- Baxter, L.W., Susan G.F. and Owen, M.G. 1982. Response of selected Camellia reticulate cultivars to Glomerella cingulata cause of contagious camellia dieback and canker. Plant disease. 66:1023-1024
- Buckley, R. J. and Gould, A. B. 2000. Botryosphaeria canker. http://aesop.rutgers.edu/~plantbiopath/links/bbcpestweb/IMAGES/cankeringrapeandbramble.pdf
- Crous, P.W., Slippers, B., Wingfield, M.J., Rheeder, J., Marasas, W.F.O., Phillips, A. J.L., Alves, A., Burgess, T., Barber, P. and Groenewald, J.Z. 2006. Phylogenetic lineages in the Botryosphaeriaceae. Studies in Mycology. 55: 235-253
- Cunnington, J.H., Priest, M.J., Powney, R.A. and Cother, N.J. Diversity of Botryosphaeria species on horticultural plants in Victoria and New South Wales. 2007. Australasian Plant Pathology. 36:157-159
- Denman, S., Crous, P.W., Taylor, E., Kang, J., Pascoe, I. and Wingfield, J. 2000. An overview of the taxonomic history of Botryospaheria, and re-evaluation of its anamorphs based on morphology and ITS rDNA phylogeny. Studies in Mycology. 45:129-140
- Dickens, J.S.W. and Cook R.T.A. 1989. Glomerella cingulata on Camellia. Plant Pathology. 38: 75-85
- J. A. Duke. 1983. Handbook of Energy Crops. Unpublished. <http://www.hort.purdue.edu/newcrop/duke_energy/camellia_sinensis.html>
- Mansilla, P., Salinero, C., Pérez, R. And Pintos, C. 2002. Plagas, enfermedades y fisiopatías de la camelia. Ed. Xunta de Galicia, 94pp.
- Pennycook, S.R. and Samuels, G.J. 1985. Botryosphaeria and Fusicoccum species associated with ripe fruit rot of Actinidia deliciosa (Kiwifruit) in New Zealand. Mycotaxon. 24: 445-458
- Phillips, A.J.L., Fonseca, F., Povoa, V., Castilho, R. and Nolasco, G. 2002. A reassessment of the anamorphic fungus Fusicoccum luteum and description of its teleomorph Botryosphaeria lutea sp. Nov. Sydowia 54: 59 -77
- Pintos, C. Mansilla, P. and Aguín, O. 2003. First Report of Phytophthora ramorum on Camellia japonica in SpainPlant Disease. 87:1396
- White, T.J., Bruns, T.D., Lee, S.B. and Taylor, J.W. 1990. Analysis of phylogenetic relationships by amplification and direct sequencing of ribosomal RNA genes. In: MD Innis, DH Gelfrand, JJ Sninsky and TJ White (eds.), PCR Protocols: A Guide to Methods and Applications: 315-322. Academic Press. San Diego. USA.
Web design by Tribal Systems